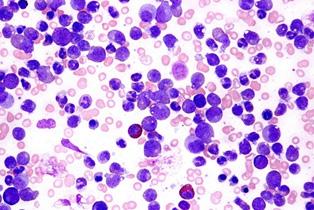

2 minute read
22. LEUCEMIA CRÓNICA MIELOIDE (LCM)
Generalidades
La leucemia es una neoplasia hematológica que nace en la médula ósea, se clasifica como crónica ya que la célula que prolifera es una célula maligna en maduración y se dirá que es mieloide porque los leucocitos que proliferan son de la estirpe mieloide.
Advertisement
La LCM es considerado como uno de los 4 tipos de síndromes mieloproliferativos crónicos, junto a policitemia vera, mielofibrosis idiopática y trombocitosis esencial.
Recuerda
Cuándo un cromosoma o parte de él se une a otro cromosoma se llama translocación. (ENAM 2011)
Fisiopatología
Etiología
Es de causa desconocida, pero se asocia a la translocación adquirida entre el cromosoma 9 y 22, esto formará el cromosoma Filadelfia, el cual está presente en el 95% de pacientes con LCM. El cromosoma Filadaldia brinda un buen pronóstico. (ENAM 2017)
El cromosoma Filadelfia, el cual se adquiere por una translocación entre el cromosoma 9 y 22, formará un oncogen llamado BCR-ABL el cual se traduce en una tirosin kinasa, esta estimula la proliferación celular de manera acelerada y descontrolada en la médula ósea. Las células que proliferan son células de la estirpe mieloide en maduración, esto hace que las demás células normales de la médula ósea sean desplazadas. Las células que salgan a la sangre serán en gran cantidad células mieloides neoplásicas y en poca cantidad las demás células normales (eritrocitos, plaquetas y linfocitos). Las células mieloides neoplásicas suelen ser con mayor frecuencia los neutrófilos, aunque también los basófilos y eosinófilos, e incluso monocitos. Las células neoplásicas también llegan a infiltrar tejidos como bazo, hígado y ganglios.
Recuerda
En la LCL es más frecuente las adenopatías que la visceromegalia, pero en la LCM es más frecuente la visceromegalia que las adenopatías.
Diagnóstico
Clínica
La presentación del paciente lo podemos dividir en tres fases:
Fase crónica
Fase acelerada
Fase blástica
La fase crónica se caracteriza por signos de anemia (cansancio, fatiga, palidez), plaquetopenia (petequias, equimosis, sangrados), linfopenia y leucocitosis por mielocitos no funcionantes (infecciones), además por la gran proliferación de leucocitos neoplásicos en sangre puede ocasionar signos de leucostasis (alteraciones visuales, cefalea, obnubilación, priapismo). También cursará con síntomas generales y dolores óseos. En la fase acelerada los leucocitos aumentan aún más, tienen menor maduración, anecdóticamente cursa con trombocitosis y liberación de células blásticas y un empeoramiento clínico con fiebre, sudoración y mayor esplenomegalia. La fase blástica es la transformación de la LCM en una LAM (con mayor frecuencia) o también como una LAL.
Exámenes
Hemograma: anemia, plaquetopenia, gran leucocitosis (entre 50 a 250 mil células/mm3) con neutrofilia, eosinofilia y basofilia. En la fase acelerada cursará con trombocitosis e incluso células blásticas. En la fase blástica habrá células blásticas.
Aspirado de médula ósea: brinda el diagnóstico y se encontrara una hipercelularidad mieloide.
Recuerda
La LCM es la leucemia que más leucocitosis genera.
Tratamiento
Figura 37. Lámina periférica con gran cantidad de leucocitos en LCM
En la fase crónica el manejo se basa en quimioterapia siendo la de elección el imatinib, pero como tratamiento curativo se tiene al trasplante de progenitores hematopoyéticos (TPH). Para la fase acelerada o blástica no hay manejo efectivo, aunque podría usarse el imatinib o TPH.
Pronóstico
Su pronóstico ha mejorado gracias al imatinib con una supervivencia hasta 90% en 5 años. El 80 a 90% fallecen por cursar con una crisis blástica.